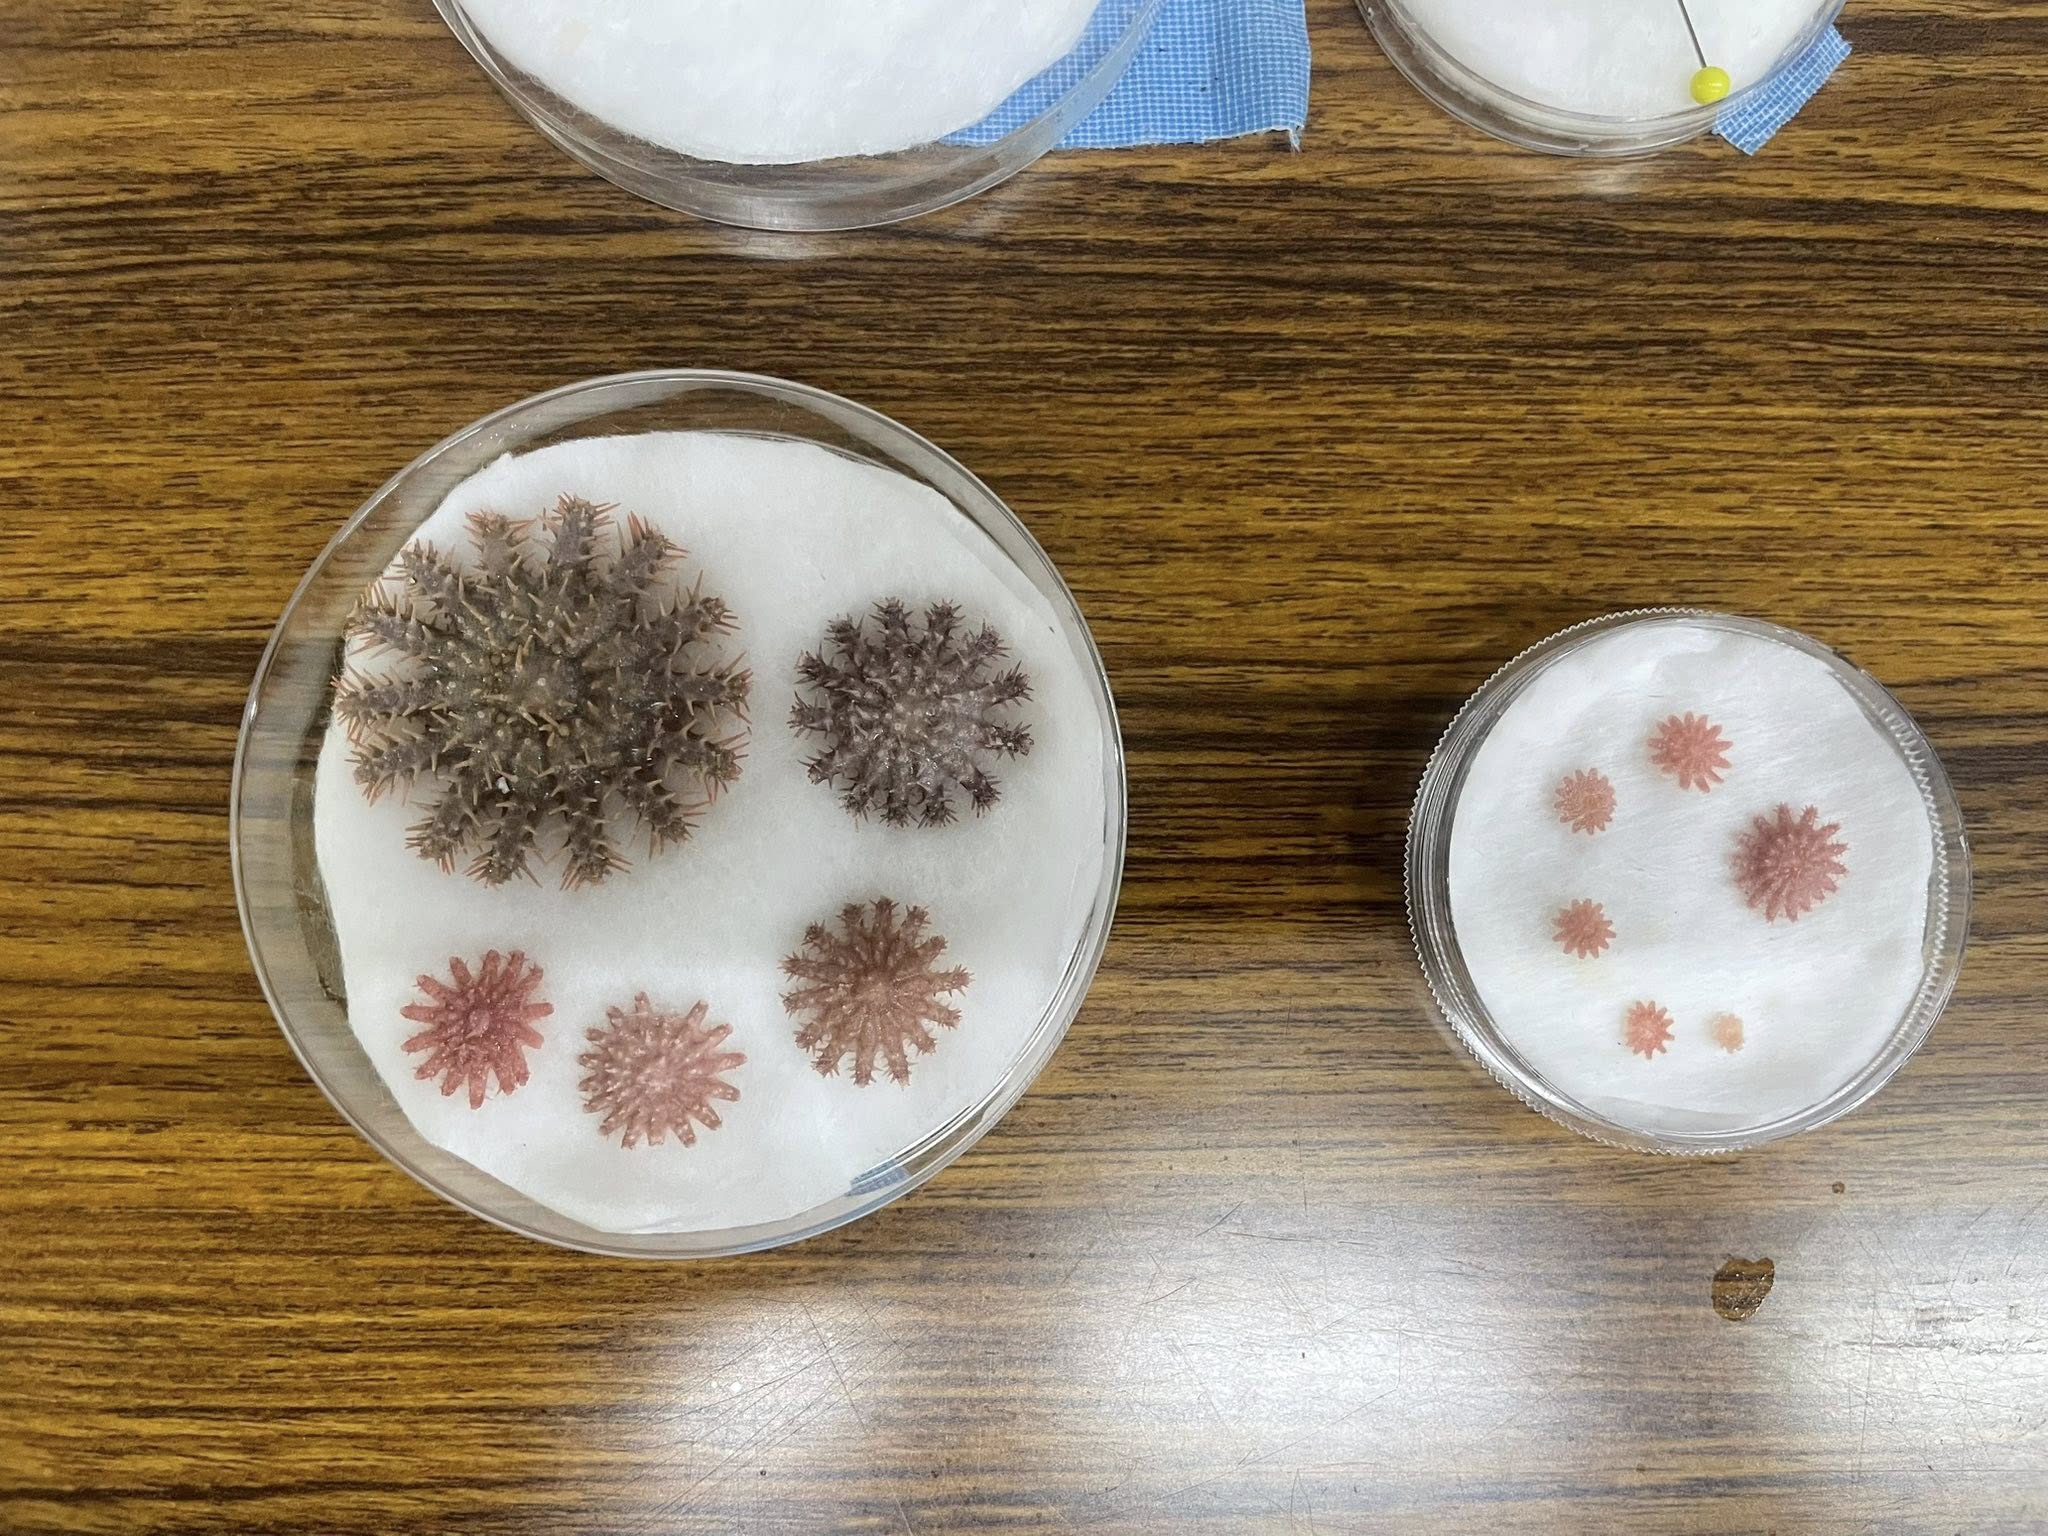

NEWSお知らせ
2025.11.25
オニヒトデの稚児モニタリング講習会に参加してきました。
このたび、沖縄環境科学センターにて開催された「オニヒトデとモニタリング手法」に関する講習会に参加しました。
オニヒトデはサンゴを主な餌とし、大量発生した場合、サンゴ礁に壊滅的な被害を与えるとともに、観光業・漁業をはじめとする地域産業や生態系全体に深刻な影響を及ぼします。持続可能な海洋環境の維持は、沖縄という地域に根ざして事業を行う私たちにとって、決して他人事ではありません。
20数年前、沖縄で実際にオニヒトデの大発生が起きた際、サンゴは失われ、かつての美しい海景色が一変しました。当時の光景は、いまも強く記憶に残っています。その経験があるからこそ、今回の学びは非常に重要な機会となりました。

講習では、
・オニヒトデ増加の背景
・発生の周期や傾向
・早期発見と対策の具体的手法
について学びました。
特に印象的だったのは、「発生後の対処」ではなく、「発生を未然に防ぐための予測と行動」に重点が置かれている点です。稚ヒトデの出現状況を継続的にモニタリングすることで、将来的な大発生の兆候を把握し、早期の対応につなげる仕組みが構築されています。
また、オニヒトデの異常発生には、海だけでなく山や川、生活排水など、私たちの暮らしと深く結びついている陸域の環境も影響している可能性があるとの説明もありました。海を守ることは、日々の生活や社会のあり方を見直すことにもつながる。そうした「海と人の循環」を改めて考えさせられる内容でした。

講習後には、実際の海域で「稚ヒトデモニタリング」の実践にも参加しました。今回の調査では稚ヒトデは1体のみの確認となり、成体も1体見つかりましたが調査対象外でした。現状が落ち着いていることに安堵すると同時に、今後も継続的な監視と意識づけが必要であることを実感しました。
当社は、海に関わる事業や地域とのつながりを大切にする企業として、今後もこうした環境保全活動や学びへの参加を継続し、持続可能な海と地域社会の実現に微力ながら貢献してまいります。
本活動の詳細については、以下のWebサイトでも紹介されています。
ご興味のある方は、ぜひご覧ください。
https://onihitode.okinawa/